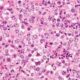
Consecuencias de la criptoorquidia

La tuberculosis intestinal es una enfermedad infecciosa crónica que afecta al sistema digestivo y es principalmente causada por las bacterias Mycobacterium tuberculosis y Mycobacterium bovis. Aunque la tuberculosis es conocida por su predominancia en los pulmones, también puede afectar a otras partes del cuerpo, entre ellas el tracto gastrointestinal, donde la manifestación más frecuente es la afectación del intestino.
La prevalencia de la tuberculosis intestinal varía considerablemente dependiendo de factores geográficos, socioeconómicos y de salud pública. En los países subdesarrollados, donde prevalecen condiciones de vida más insalubres, una nutrición deficiente y un acceso limitado a servicios de salud, la tuberculosis intestinal es más común. En estos entornos, la transmisión de la bacteria Mycobacterium tuberculosis, a través de la inhalación de aerosoles contaminados, suele ser más frecuente, y la propagación hacia otros órganos, como el tracto gastrointestinal, puede ocurrir cuando la bacteria se disemina por el torrente sanguíneo o por vía linfática. Además, en muchas de estas regiones, los sistemas de control de enfermedades, incluyendo la detección temprana de la tuberculosis y el tratamiento adecuado, son deficientes, lo que contribuye a la persistencia y el aumento de la carga de la enfermedad.
En contraste, en países desarrollados como Estados Unidos, la tuberculosis intestinal es una afección rara. Esto se debe principalmente a un conjunto de factores: una mayor disponibilidad de diagnóstico temprano, acceso a tratamientos eficaces y la implementación de programas de salud pública que controlan la propagación de la enfermedad. Sin embargo, existen ciertos grupos de población en los que la tuberculosis intestinal sigue siendo relevante. Uno de ellos son los inmigrantes provenientes de países donde la tuberculosis es endémica, quienes pueden estar en riesgo debido a la exposición a la enfermedad antes de emigrar. Otro grupo vulnerable es el de los pacientes con SIDA no tratado o con sistemas inmunitarios comprometidos, ya que la inmunosupresión favorece la reactivación de infecciones latentes, incluida la tuberculosis, que en estos individuos puede manifestarse de manera extrapulmonar, afectando el tracto gastrointestinal.
La tuberculosis intestinal se caracteriza por su afectación más frecuente en la región ileocecal del tracto gastrointestinal, aunque cualquier parte del sistema digestivo puede verse involucrada. La región ileocecal es especialmente vulnerable debido a la presencia de una gran cantidad de tejido linfoide, que facilita la colonización de las bacterias. Esta forma de la enfermedad es de lenta evolución y puede ser difícil de diagnosticar, ya que sus síntomas pueden ser similares a los de otras afecciones gastrointestinales, como la enfermedad inflamatoria intestinal, y pueden incluir dolor abdominal, pérdida de peso, diarrea crónica y obstrucción intestinal. Sin embargo, la tuberculosis intestinal puede presentarse en formas más graves, como la perforación intestinal o la hemorragia, lo que representa una amenaza significativa para la salud del paciente.
En cuanto a la manifestación clínica de la enfermedad, se observa que menos del 50% de los pacientes con tuberculosis intestinal presentan enfermedad pulmonar activa, lo que hace que la tuberculosis intestinal sea una forma de presentación extrapulmonar, lo que a su vez complica el diagnóstico y tratamiento. La falta de sintomatología pulmonar activa en muchos casos es uno de los factores que contribuye a que la tuberculosis intestinal pase desapercibida en muchas ocasiones.
Manifestaciones clínicas
La tuberculosis intestinal es una manifestación extrapulmonar de la infección por Mycobacterium tuberculosis o Mycobacterium bovis, que afecta el tracto gastrointestinal, y su presentación clínica puede ser bastante variable, lo que dificulta tanto su diagnóstico temprano como su manejo adecuado. En muchos pacientes, los síntomas pueden ser mínimos o incluso ausentes, especialmente en las etapas iniciales de la enfermedad. Esto se debe a la naturaleza crónica de la infección y a su capacidad para progresar de forma insidiosa, lo que permite que el organismo se adapte a la presencia de la bacteria sin generar una respuesta inmunológica inmediata y evidente. Como resultado, los pacientes pueden no experimentar síntomas evidentes o pueden presentar signos clínicos que se desarrollan de manera gradual, haciendo que la enfermedad pase desapercibida durante un tiempo considerable.
Uno de los síntomas más comunes que reportan los pacientes con tuberculosis intestinal es el dolor abdominal crónico. Este dolor suele ser intermitente y puede localizarse en diferentes áreas del abdomen, aunque la región ileocecal es la más afectada debido a su proximidad al lugar donde se produce una mayor inflamación y ulceración. Este dolor puede ser difícil de diferenciar de otras afecciones gastrointestinales, como el síndrome del intestino irritable o la enfermedad inflamatoria intestinal, por lo que puede requerir una evaluación más exhaustiva para llegar a un diagnóstico certero.
Además del dolor abdominal, muchos pacientes presentan síntomas obstructivos. Estos incluyen distensión abdominal, náuseas, vómitos y sensación de plenitud postprandial. La obstrucción intestinal puede ocurrir cuando la inflamación, el engrosamiento de las paredes intestinales o la formación de masas tumorales resultan en una disminución del diámetro del lumen intestinal, lo que impide el paso normal de los alimentos y los desechos. En algunos casos, el proceso inflamatorio puede progresar a la formación de una estenosis intestinal, que es un estrechamiento del intestino que limita aún más la movilidad del contenido intestinal y provoca una obstrucción mecánica.
La pérdida de peso es otro síntoma característico en pacientes con tuberculosis intestinal. Esta puede ser causada por una combinación de factores, incluyendo la mala absorción de nutrientes debido a la inflamación crónica del intestino, el aumento del metabolismo por la fiebre o las infecciones sistémicas, y una ingesta insuficiente de alimentos debido a la anorexia o el dolor durante la digestión. La pérdida de peso, a menudo acompañada de fatiga generalizada, es una manifestación de la malnutrición asociada con la enfermedad, y su presencia puede indicar un deterioro significativo en el estado de salud del paciente.
Otro síntoma común es la diarrea, que puede presentarse de forma crónica o intermitente. La diarrea en la tuberculosis intestinal suele ser consecuencia de la inflamación y ulceración del revestimiento intestinal, lo que afecta la capacidad del intestino para absorber agua y electrolitos de los alimentos procesados. En algunos casos, la diarrea puede ser acompañada de sangre o moco, lo que sugiere una afectación más severa del tracto gastrointestinal. La diarrea persistente también contribuye a la desnutrición y al agotamiento del paciente, lo que empeora su estado general.
En cuanto al examen físico, uno de los hallazgos más comunes en los pacientes con tuberculosis intestinal es la palpación de una masa abdominal. Esta masa suele ser dura y dolorosa al tacto y está asociada con la inflamación crónica y la formación de adenopatías mesentéricas o abscesos. Las masas pueden formarse debido a la acumulación de tejido inflamatorio en las áreas afectadas del intestino, lo que lleva a la aparición de una tumefacción palpable en el abdomen. En algunos casos, esta masa puede estar localizada en el área ileocecal, que es el sitio más frecuentemente afectado por la tuberculosis intestinal.
Las complicaciones de la tuberculosis intestinal pueden ser graves y representan una amenaza significativa para la salud del paciente. Entre las más comunes se encuentran la obstrucción intestinal, la hemorragia y la formación de fístulas. La obstrucción intestinal, como se mencionó anteriormente, puede ser consecuencia de la inflamación crónica, el engrosamiento de las paredes intestinales o la formación de un granuloma que reduce el lumen del intestino. Esta obstrucción puede ser parcial o total, y cuando es severa, puede requerir intervención quirúrgica de urgencia.
La hemorragia gastrointestinal es otra complicación potencialmente grave. El proceso inflamatorio asociado con la tuberculosis intestinal puede causar ulceración de la mucosa intestinal, lo que lleva a la ruptura de los vasos sanguíneos en la zona afectada. Como resultado, el paciente puede presentar sangre en las heces o en el vómito, lo que indica la presencia de hemorragias activas. En casos extremos, las hemorragias pueden ser masivas y poner en peligro la vida del paciente, requiriendo una intervención médica inmediata.
La formación de fístulas es una complicación menos común, pero igualmente seria. Las fístulas son conexiones anormales entre diferentes partes del intestino o entre el intestino y otros órganos, como la vejiga, la piel o los órganos reproductivos. Estas formaciones son el resultado de la penetración de la inflamación a través de la pared intestinal y pueden causar una serie de problemas, como infecciones secundarias, peritonitis o incluso perforación intestinal. Las fístulas pueden requerir un tratamiento quirúrgico para corregirlas y evitar que se desarrollen infecciones graves.
Exámenes diagnósticos
La prueba cutánea de derivado proteico purificado (PPD) es una herramienta comúnmente utilizada para la detección de la tuberculosis (TB) mediante la medición de la respuesta inmune del organismo al introducir un extracto proteico de Mycobacterium tuberculosis en la piel del paciente. Sin embargo, esta prueba no siempre es confiable, especialmente en ciertos grupos de pacientes, como aquellos con pérdida de peso significativa o pacientes con síndrome de inmunodeficiencia adquirida (SIDA). La razón detrás de una respuesta negativa en estos casos radica en la interacción entre el sistema inmunológico debilitado y la prueba misma.
En individuos inmunocomprometidos, como aquellos con SIDA o con una pérdida de peso significativa debido a enfermedades crónicas, el sistema inmunológico presenta una respuesta disminuida a los estímulos antigénicos. Las células T, que son las responsables de la respuesta inmunitaria mediada por hipersensibilidad retardada, pueden no estar suficientemente activadas o funcionales debido a la inmunodeficiencia. En el contexto del SIDA, la infección por el virus de la inmunodeficiencia humana (VIH) provoca una reducción en el número y la función de las células T CD4+, las cuales son cruciales para una respuesta efectiva a la tuberculosis. Por lo tanto, incluso si un paciente está infectado por Mycobacterium tuberculosis, la prueba PPD puede no desencadenar una respuesta positiva, lo que lleva a un falso negativo.
Este fenómeno es particularmente relevante en pacientes con SIDA en fases avanzadas, ya que estos individuos pueden desarrollar formas extrapulmonares o diseminadas de tuberculosis, donde la respuesta inmunitaria local es insuficiente para controlar la proliferación de la bacteria. De este modo, la falta de una respuesta inmune efectiva no solo influye en la prueba cutánea, sino que también aumenta el riesgo de que la enfermedad se manifieste de manera más agresiva, sin los típicos signos de infección pulmonar.
En cuanto a los hallazgos radiológicos, la tomografía abdominal en pacientes con tuberculosis intestinal puede mostrar engrosamiento de la mucosa del ciego y la válvula ileocecal, así como linfadenopatía masiva, lo que sugiere una posible afectación de los ganglios linfáticos mesentéricos. La tuberculosis intestinal, especialmente cuando es extrapulmonar, es un fenómeno relativamente raro, pero puede manifestarse con síntomas inespecíficos como dolor abdominal, diarrea y pérdida de peso. El engrosamiento del ciego y la válvula ileocecal puede ser una manifestación secundaria de la respuesta inflamatoria a la infección bacteriana.
La colonoscopia, por su parte, puede revelar diversos hallazgos característicos. Entre ellos se incluyen la presencia de una masa ulcerada en el tracto intestinal, múltiples úlceras con bordes pronunciados y pólipos sésiles pequeños adyacentes, así como úlceras o erosiones pequeñas. Estos hallazgos no son exclusivos de la tuberculosis, ya que también pueden observarse en otras condiciones gastrointestinales inflamatorias o malignas. Sin embargo, la localización más común de estas lesiones en la región ileocecal es un indicio importante de tuberculosis intestinal, dada la anatomía y la distribución de las lesiones en esta forma extrapulmonar de la enfermedad.
El diagnóstico diferencial de la tuberculosis intestinal incluye varias patologías, como la enfermedad de Crohn, el carcinoma, el linfoma y la amebiasis intestinal, todas las cuales pueden presentar hallazgos similares en imágenes y en la observación endoscópica. La enfermedad de Crohn, por ejemplo, también puede involucrar la región ileocecal, con la formación de úlceras y la presencia de pólipos, lo que puede complicar el diagnóstico clínico. El linfoma y el carcinoma también pueden causar masa y linfadenopatía en la misma área. La amebiasis intestinal, por otro lado, podría dar lugar a úlceras y alteraciones en la mucosa, pero su etiología y el tratamiento son completamente distintos.
Para establecer el diagnóstico definitivo de tuberculosis intestinal, se requiere una biopsia endoscópica o quirúrgica que permita la identificación de bacilos ácido-alcohol resistentes, característicos de Mycobacterium tuberculosis. El análisis histológico puede revelar la presencia de granulomas caseosos, una característica patognomónica de la tuberculosis, aunque no exclusiva de esta enfermedad. El cultivo bacteriológico, aunque útil, tiene una sensibilidad limitada en casos extrapulmonares debido a la baja carga bacteriana en el tejido afectado. Por esta razón, la detección de Mycobacterium tuberculosis en muestras de biopsia mediante la reacción en cadena de la polimerasa (PCR) ha emergido como una de las técnicas más sensibles para el diagnóstico de tuberculosis intestinal. La PCR permite la identificación de material genético del patógeno con alta precisión, incluso en muestras con bajo número de bacilos, lo que mejora significativamente la capacidad diagnóstica frente a métodos tradicionales.
Tratamiento
El tratamiento de la tuberculosis intestinal, al igual que el de otras formas de tuberculosis extrapulmonar, se basa en la utilización de regímenes estándar antituberculosos que son eficaces para erradicar la infección sistémica causada por Mycobacterium tuberculosis, el agente etiológico de la enfermedad. La tuberculosis intestinal, aunque menos común que la pulmonar, se presenta como una forma extrapulmonar que afecta principalmente al tracto gastrointestinal, especialmente a la región ileocecal, el ciego y el colon. El tratamiento se fundamenta en la necesidad de combatir la bacteria tanto de manera local, en el sitio de la infección, como a nivel sistémico, dado que la tuberculosis intestinal puede ser parte de una infección diseminada que afecta otros órganos y sistemas.
Los regímenes estándar para el tratamiento de la tuberculosis intestinal consisten en una combinación de fármacos antibióticos, que actúan sobre Mycobacterium tuberculosis en diferentes fases de su ciclo de vida, con el objetivo de erradicar la infección y prevenir la resistencia a los medicamentos. El tratamiento de la tuberculosis generalmente sigue un enfoque de «quimioterapia combinada», que incluye el uso de varios fármacos antituberculosos que tienen actividad contra la bacteria y que, al administrarse de forma conjunta, potencian su eficacia y reducen el riesgo de que la bacteria desarrolle resistencia.
El esquema más comúnmente utilizado para tratar la tuberculosis intestinal es el mismo que se emplea para la tuberculosis pulmonar y otras formas extrapulmonares, basado en un tratamiento inicial intensivo seguido de una fase de mantenimiento. Este esquema se basa en la combinación de cuatro fármacos: rifampicina, isoniazida, pirazinamida y etambutol, durante los primeros dos meses de tratamiento. En fases posteriores, cuando la carga bacteriana ha disminuido considerablemente, el tratamiento se reduce a dos fármacos, principalmente rifampicina e isoniazida, durante un período adicional de cuatro a seis meses, según la respuesta clínica y la ausencia de complicaciones.

Fuente y lecturas recomendadas:
- Mor P et al. Recent updates in diagnosis of abdominal tuberculosis with emphasis on nucleic acid amplification tests. Expert Rev Gastroenterol Hepatol. 2022;16:33. [PMID: 34923892]